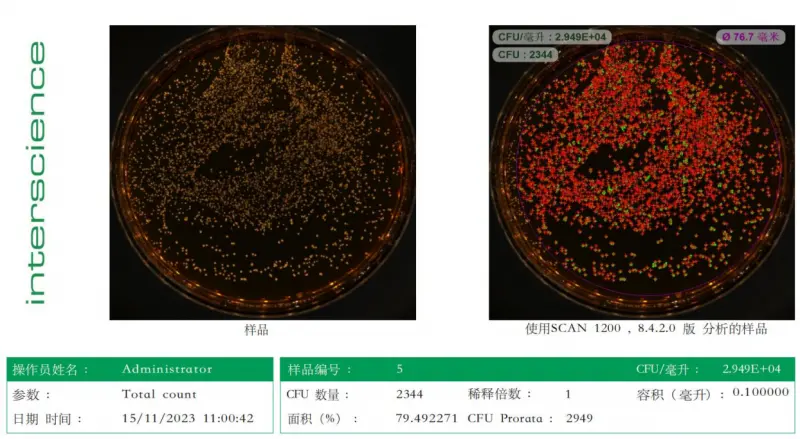

益生菌,被世界卫生组织定义为“当摄入足够量时,可为宿主带来健康益处的活微生物”。近年来,随着国民健康意识的显著提升,多元化的益生菌产品渐渐成为消费新风尚,销量持续上扬。然而,这股市场热潮的背后,夸大宣传、以次充好、菌株信息标注模糊等问题频现,让消费者面对琳琅满目的产品难以辨别真伪。
在此背景下,浙江悠尼恩生物科技有限公司(以下简称悠尼恩)应运而生,以其专业与专注,为益生菌市场带来了新气象。

作为专注于人体微生态领域的品牌,悠尼恩积极与国际顶级益生菌企业,如丹麦科汉森、AB-Biotics等展开深度合作,引进经长期研究及临床测试的优质菌株,以高标准、高活性的益生菌产品,为国民健康福祉筑起一道坚实的防线。
明确菌株信息,拒绝给用户“打哑谜”
在益生菌产品的选择上,消费者往往面临着信息不对称的困境。市面上多数益生菌产品仅罗列菌种而没有菌株号,并模糊地标注“添加量”“含量”,让产品中的活菌数量普遍成“谜”。
悠尼恩则坚决拒绝这种“打哑谜”的行为,其产品配方上明确标注了菌株及菌株号,让消费者一目了然。同时,悠尼恩还严选源自国际顶尖益生菌工厂的菌株,从源头保障产品的安全有效。
以悠尼恩蓓合益益生菌为例,其主要成分动物双歧杆菌Bb-12与鼠李糖乳杆菌LGG,均获得丹麦科汉森正规授权。这两大菌株不仅有着大量的科学论文、临床研究的支持,更拥有几十年的安全使用历史。
而悠尼恩8330益生菌、蓓舒益(AB-Kolicare)益生菌及蓓纤益(lipigo)后生元等产品也获得AB-Biticos公司正规授权。这些与国际顶尖益生菌工厂的深度合作,无疑是对悠尼恩益生菌产品高品质与可靠性的有力证明。

高活性低致敏,筑牢国民健康防线
益生菌的活性是其发挥功效的关键所在。为了确保菌株的活性,悠尼恩采用了先进的ICP液体萃取技术,使菌株更好地分散在油脂里,从而保证了菌株的活性与稳定性。
在进入国内市场前,悠尼恩还会对菌株进行活性抽检,并通过国家相关部门的严格检测,确保菌株活性高达80%以上。正是这样的高标准、严要求,让消费者吃到的是真正的高活性益生菌。
对于过敏人群来说,选择益生菌产品往往更加谨慎。悠尼恩益生菌则以其低致敏性赢得了过敏人群的信赖。其产品采用高纯度小分子葵花籽油作为辅料,不含常见致敏原,并经新西兰食品药品营养学院相关人体临床研究证实,过敏人群也可安心食用。这一贴心设计,让悠尼恩益生菌成为了更多人的健康选择。
产品口碑载道,获医生及专家认可
面对激烈的市场竞争与不断变化的市场需求,悠尼恩并没有拘泥于单一的推广方式,而是采取医务线+母婴线并行的策略,积极拓展市场。
在医务线方面,悠尼恩与全国多家三甲级以上的医院和药店展开合作,临床上得到了众多医生及专家的认可。在母婴线方面,悠尼恩则凭借其高品质的产品和专业的服务,赢得了全国几千家母婴店的青睐,消费者回购率稳居高位。同时,完善的售后体系,也进一步提升了悠尼恩的品牌美誉度和忠诚度。
虽然益生菌产品成为消费新风尚,但不少生产商和消费者只是“盲从”,缺乏对益生菌的正确认识。悠尼恩积极行动,联合中国妇幼保健协会科学喂养组及中国营养学会教育培训中心,多次开展母婴及微生态相关的大型教育科普课程,旨在提升消费者对益生菌的认知力和辨别力,推动益生菌行业的健康发展。

在我国益生菌行业迈向高质量发展的进程中,构建适配国人的高标准菌株库至关重要。2023年,悠尼恩成立了微生物代谢免疫产品研究中心,集结专家力量,深入探究消化道微生态与健康关联,并积极寻找中国本土菌株。这不仅是对国民健康的深情承诺,更是作为行业佼佼者的责任与担当。展望未来,悠尼恩将奋力构建更贴合国人的高标准菌株库,为国民健康贡献力量。
